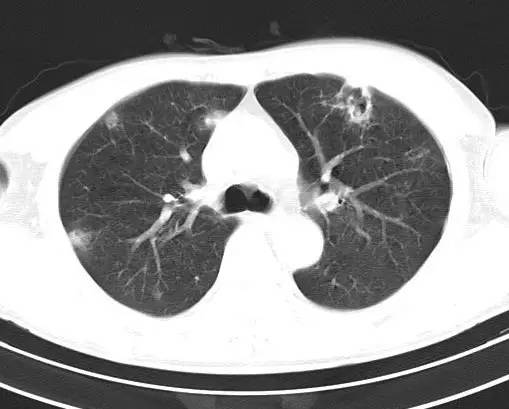
【病例】金黄色葡萄球菌肺炎1例CT影像表现
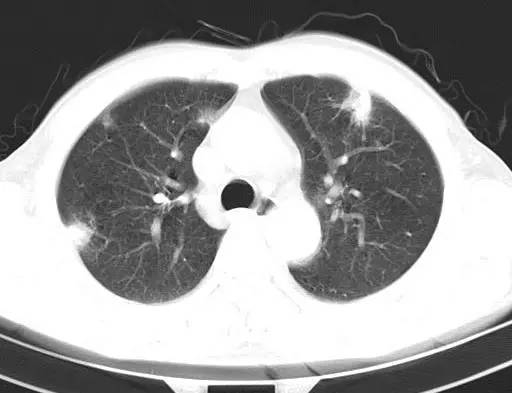
【病例】金黄色葡萄球菌肺炎1例CT影像表现

【病例】金黄色葡萄球菌肺炎1例CT影像表现
发布时间:2022-10-21
发布时间:2022-10-21
病程描述
男,63岁,咳嗽半月,血常规检查正常,典型化脓性肺炎,治疗10天复查。

[影像描述]
治疗前CT(图1-8):两肺胸膜下散在多发斑片状、结节状伴空洞影,边缘欠清晰。
治疗后十天CT(图9-12):双肺病灶明显缩小,有所吸收。
[检查结果]
金黄色葡萄球菌肺炎,抗炎治疗23天后完全吸收。
[讨论]
疾病早期CT改变不明显。仅有小片状肺部浸润。病变发展极快。出现大叶性炎症改变或肺段性浸润,常以双下肺野多见。随后病灶内或其周围出现空腔或蜂窝状透亮区,并可发展为肺脓肿。肺浸润、肺脓肿、肺气囊肿和脓胸或脓气胸为金黄色葡萄球菌肺炎的四大影像征象
为多发性肺脓肿、肺气囊肿、脓胸,并可产生张力性气胸、纵隔气肿。金黄色葡萄球菌肺炎的另一特征呈迁徙性,当临床表现已明显缓解时肺气囊肿仍可存在数月,最后可自然痊愈。血源性葡萄球菌肺炎早期在双肺的周边部出现大小不一的斑片状或团块状阴影,边缘模糊,直径为1~3cm,有时类似于转移性肺癌,随病变发展,病灶周围出现肺气囊肿,并迅速发展成肺脓肿。
鉴别诊断
1.起病急。临床症状重。
2.表现多样,多种影像表现可同时出现,如斑片状影、小点状影、结节影、肺气囊等可在CT片上同时见到;
3.病灶比较广泛,多个肺野出现同时受累;
4.容易在短期内出现散在的肺气囊或多发的脓肿病灶;
5.病灶易变,短期内复查CT可见病灶的形态、部位、大小发生变化。